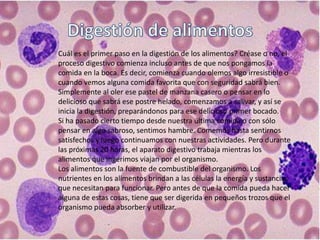
Cuál es el primer paso en la digestión de los alimentos? Créase o no, el
proceso digestivo comienza incluso antes de que nos pongamos la
comida en la boca. Es decir, comienza cuando olemos algo irresistible o
cuando vemos alguna comida favorita que con seguridad sabrá bien.
Simplemente al oler ese pastel de manzana casero o pensar en lo
delicioso que sabrá ese postre helado, comenzamos a salivar, y así se
inicia la digestión, preparándonos para ese delicioso primer bocado.
Si ha pasado cierto tiempo desde nuestra última comida o con sólo
pensar en algo sabroso, sentimos hambre. Comemos hasta sentirnos
satisfechos y luego continuamos con nuestras actividades. Pero durante
las próximas 20 horas, el aparato digestivo trabaja mientras los
alimentos que ingerimos viajan por el organismo.
Los alimentos son la fuente de combustible del organismo. Los
nutrientes en los alimentos brindan a las células la energía y sustancias
que necesitan para funcionar. Pero antes de que la comida pueda hacer
alguna de estas cosas, tiene que ser digerida en pequeños trozos que el
organismo pueda absorber y utilizar.

El documento describe el sistema digestivo humano, incluyendo sus partes principales (boca, esófago, estómago, hígado, páncreas, intestino delgado e intestino grueso) y sus funciones. Explica que la digestión convierte los alimentos en moléculas más pequeñas que el cuerpo puede absorber y utilizar, y que es controlada por hormonas.